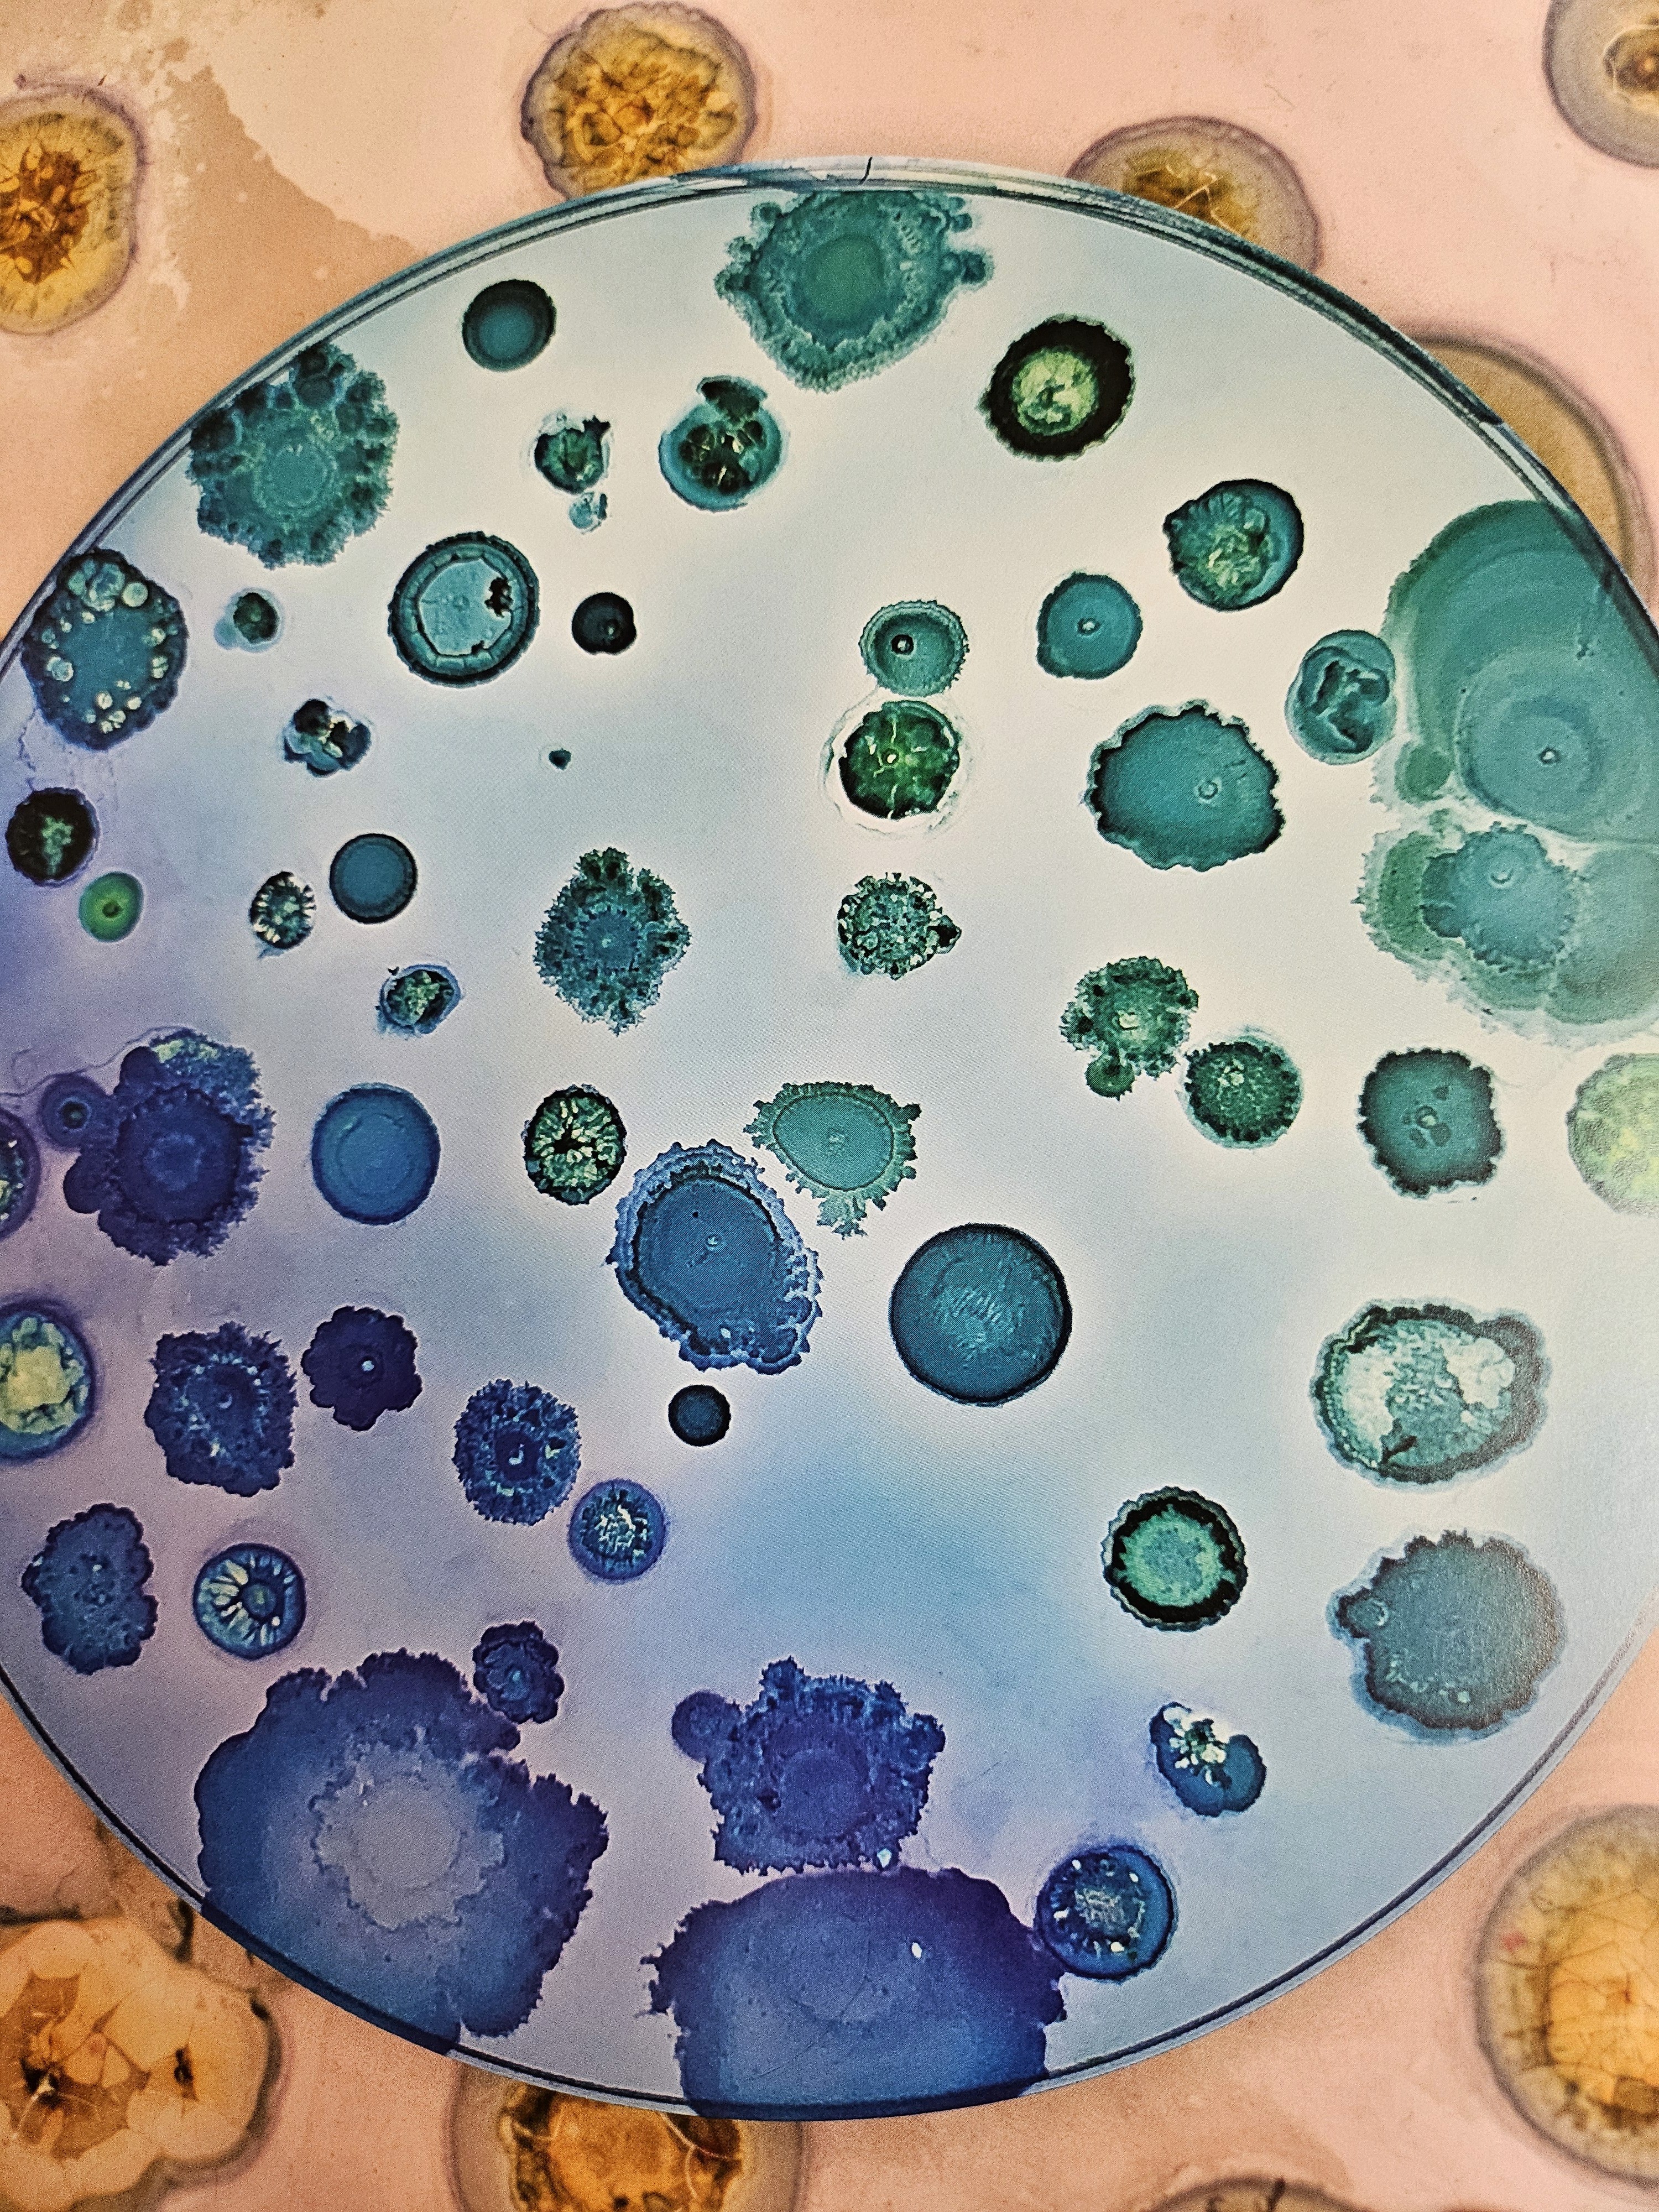

Automated colony counts with unparalleled accuracy.
Automate and digitize the QC Lab with the M6’s powerful machine learning that delivers counts in CFUs. Reduce labor spent on investigations, leading to intelligent manufacturing decisions while also increasing patient safety.
If it doesn’t grow, we don’t count it.
We don’t rely on proxies or assumptions. Our technology captures and quantifies actual microbial growth—bringing gold-standard biological methods into the era of high-speed, automated testing. Designed for regulated environments. Backed by validated microbiology.

High-Resolution Detection, Down to the Micron.
Simple Process.
Powerful Results.
Clear indicators. Smart alerts. Less room for error.
Eliminates error-prone, manual colony counting.
21 CFR Part 11 compliance and seamless LIMS integration for effortless retention and compliance.
Non-destructive testing enables easy sub-culturing and offboard identification.
The M6 hosts six independent, hot-swappable, test bays– designed for reliability and engineered for long service life.
Compact equipment footprint preserves precious benchtop real estate.
Faster results, faster inventory turns – paired with intelligent manufacturing decisions.
ready. set. go.
Join the growing number of companies modernizing their QC labs with Mango.
Get in touch
Reach out with any questions you may have or to learn more.
Email Mango